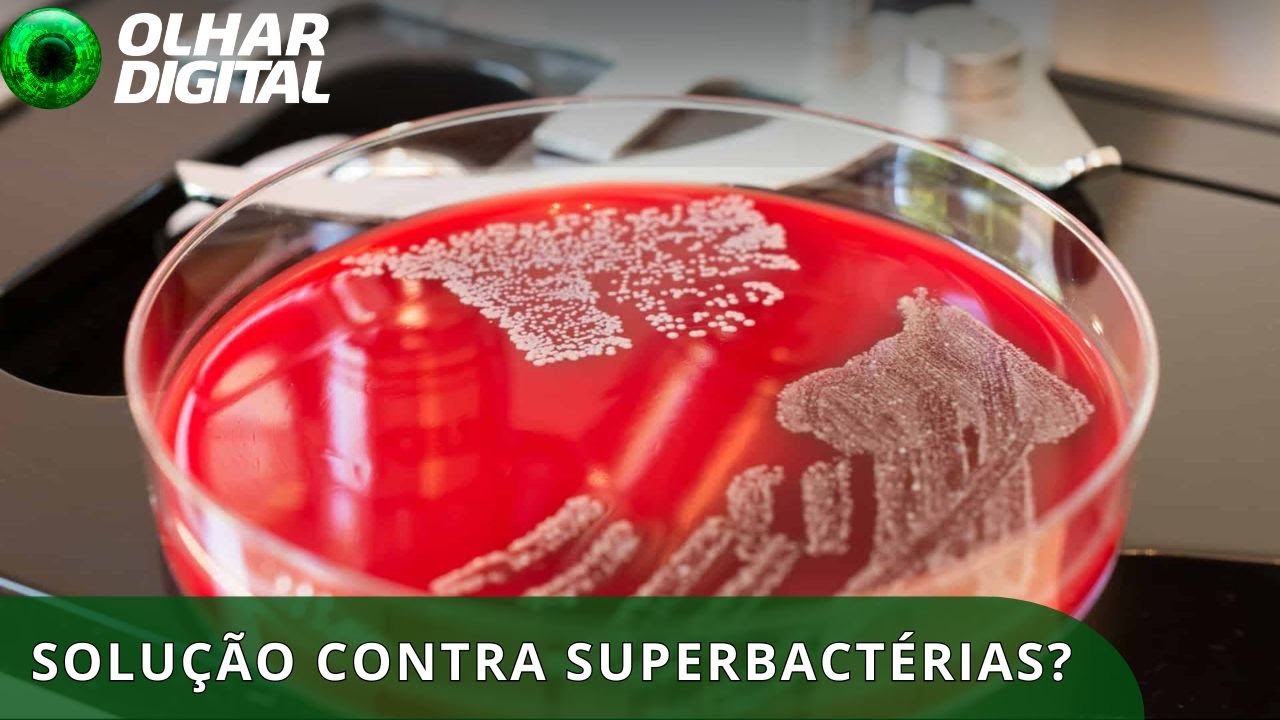
Superbactérias: brasileiros descobrem enzima que fortalece antibióticos

Posts Similares

Carro solar acesível pode vir ao Brasil
A invenção é holandesa trata-se de um Carro super compacto mas mais que o Tamanho que chama a atenção dele é a Tecnologia E também o preço ou melhor Ele pode vir ao Brasil vamos conhecer Um carrinho simpático e…

‘Relatório das Forças Armadas não exclui possibilidade de fraude’, diz Ministério da Defesa
O Ministério da Defesa divulgou uma nota Na manhã dessa quinta-feira afirmando Que o relatório das Forças Armadas sobre As eleições não exclui a possibilidade De fraude ou inconsistência nas urnas na Nota minissérie afirma que embora não Tenha apontado…

Snapdragon 8 Gen 2: confira o que oferece o novo chip da Qualcomm
Vamos conversar com o André Fogaça que Está por lá cobrindo o principal evento De um dos maiores aliás de uma das Maiores produtoras de processadores do Planeta vamos lá deixa eu colocar o André Fogaça aqui na nossa tela…



‘Taxa das blusinhas’: quanto vão custar suas compras se o imposto passar
O congresso aprovou a famosa taxa das Blusinhas né Como ficou conhecida que Tem causado preocupação a quem faz Compras internacionais ela foi para a Sanção do presidente Lula Inclusive a Gente deve ter novidades em breve o Ponto que…
